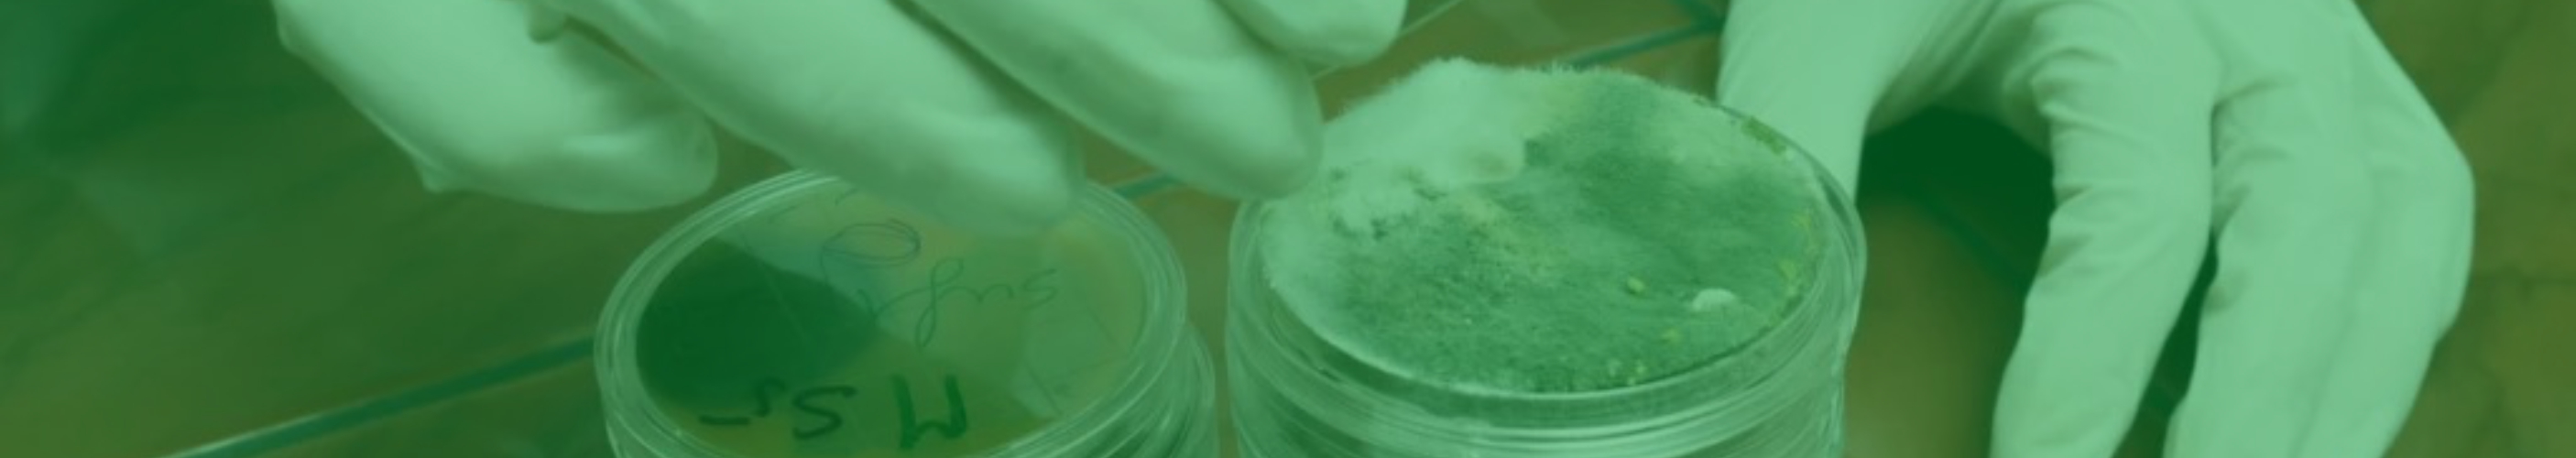
Professional mold inspection and air sampling

Asbestos Residential Testing & Inspection
Disturbing asbestos can release harmful fibers that pose serious health risks. Our certified inspectors thoroughly assess your property to identify asbestos-containing materials (ACMs) using advanced, reliable testing methods.
- Pre-renovation and demolition inspections
- Air monitoring and clearance testing
- Bulk sample analysis through accredited laboratories
- Customized management plans for residential properties
- Rapid-response emergency testing